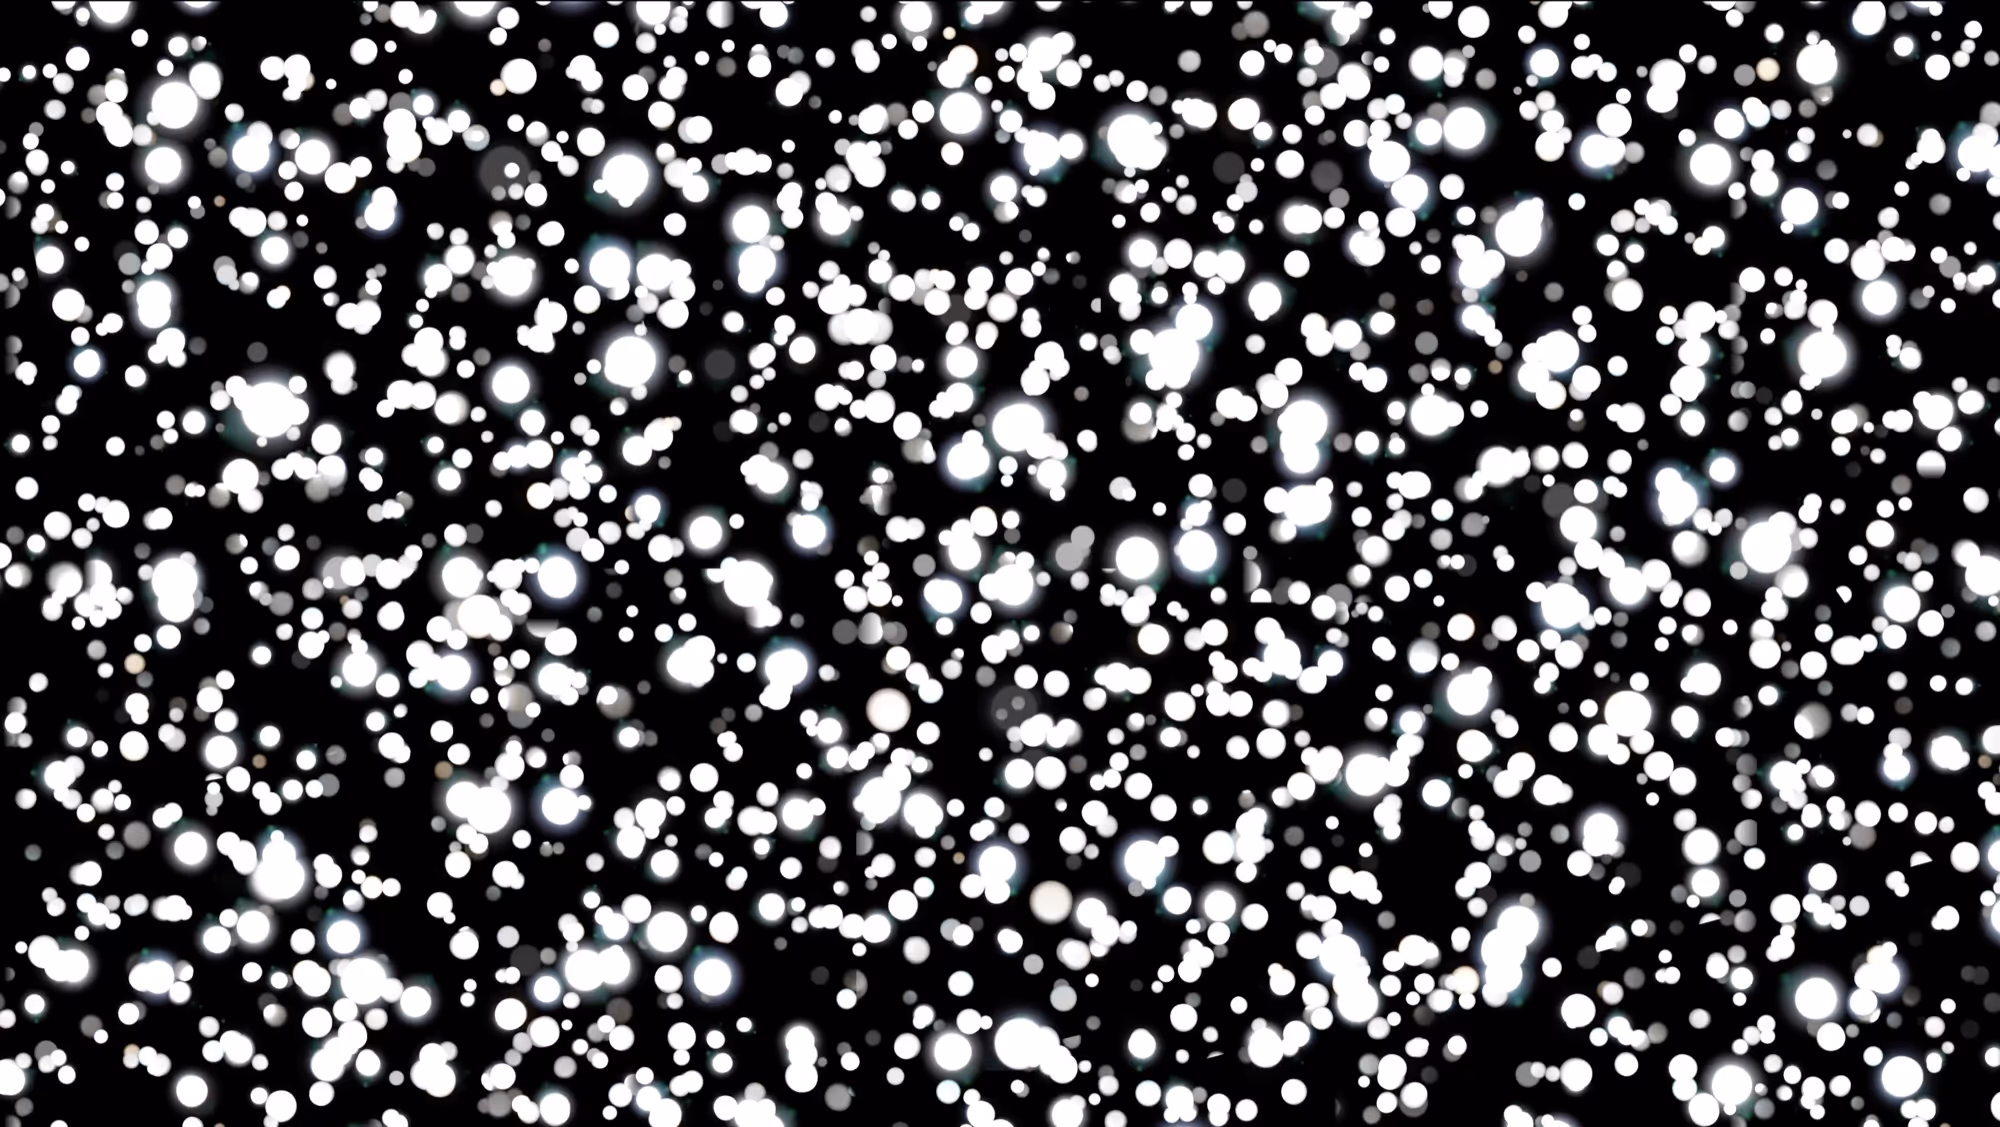

This video piece is built around a single filmed pinhole, one of the simplest and earliest forms of photography. At the centre of the piece sits a parable. Eight lines of text gesture towards a certain longing, an intuitive knowing and a sense of forces beyond one’s conscious or individual control. Through light, repetition and patterning, this work brings attention back to the act of seeing and raises questions about the material and metaphysical experiences of sight.
Tracy Abbott Szatan is a multidisciplinary light and lens artist. Working across film, photography, glass, and installation, she explores the spaces in between representation and abstraction to evoke the indefinable familiar, and to develop research-based works entangled in questioning our ways of seeing, speaking, and knowing.